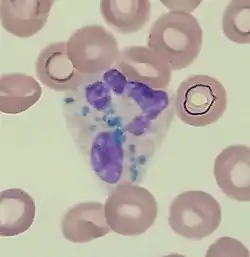
Critical green inclusions in a neutrophil

| Critical green inclusions | |
|---|---|
| Other names | Green neutrophilic inclusions, death crystals, crystals of death |
![]() | |
| Critical green inclusions in a neutrophil | |
| Specialty | Hematology |
Critical green inclusions, also known as green neutrophilic inclusions and informally, death crystals or crystals of death,[1][2] are amorphous blue-green cytoplasmic inclusions found in neutrophils and occasionally in monocytes. They appear brightly coloured and refractile when stained with Wright-Giemsa stain. These inclusions are most commonly found in critically ill patients, particularly those with liver disease, and their presence on the peripheral blood smear is associated with a high short-term mortality rate.[3][4]
Clinical significance
Critical green inclusions are a rare finding, and when found they are suggestive of a poor prognosis, hence the colloquial term death crystals. A 2018 review found that 56% of patients died shortly after the inclusions were first identified (usually within two weeks).[5] However, critical green inclusions are of limited utility for predicting mortality because they are usually found in severely ill patients whose poor prognosis is already evident for other reasons by the time the crystals are detected.[6]
The inclusions were once hypothesized to be bile products phagocytized during fulminant hepatic injury, due to the high incidence of critical green inclusions observed in cases of acute hypoxic and ischaemic hepatitis.[7] However, recent studies have highlighted that the inclusions stain positive for Oil Red O as opposed to bile stains, suggesting high lipid content.[8] Additionally, some cases with critical green inclusions were not associated with notable hepatic injury. Currently, it is suggested that critical green inclusions are more likely to be phagocytized products of lysosomal degradation related to tissue injury.[8]
Composition
The composition of the inclusions is not well understood, but transmission electron microscopy has shown that they are rich in lipids and possibly related to lipofuscin. Microscopic examination of liver tissue in patients with critical green inclusions has demonstrated prominent deposition of lipofuscin, suggesting that the white blood cell inclusions represent phagocytosis of this substance following severe injury to the liver.[3][9]
References
- ↑ Soos, M. P.; Heideman, C.; Shumway, C.; Cho, M.; Woolf, A.; Kumar, C. (2019). "Blue-green neutrophilic inclusion bodies in the critically ill patient". Clinical Case Reports. 7 (6): 1249–1252. doi:10.1002/ccr3.2196. PMC 6552944. PMID 31183104.
- ↑ Hodgkins, S. R.; Jones, J. "A case of blue-green neutrophil inclusions". ASCLS Today. 32 (4). Archived from the original on 2020-08-06. Retrieved 2019-06-12.
- 1 2 Hodgson, T. O.; Ruskova, A.; Shugg, C. J.; McCallum, V. J.; Morison, I. M. (2015). "Green neutrophil and monocyte inclusions - time to acknowledge and report". British Journal of Haematology. Wiley. 170 (2): 229–235. doi:10.1111/bjh.13434. ISSN 0007-1048. PMID 25892703. S2CID 23809865.
- ↑ Haberichter, K.; Crisan, D. (2017). "Green Neutrophilic Inclusions and Acute Hepatic Failure: Clinical Significance and Brief Review of the Literature". Annals of Clinical and Laboratory Science. Association of Clinical Scientists. 47 (1): 58–61. PMID 28249918.
- ↑ Yang, J; Gabali, A. (2018). "Green neutrophilic inclusions: current understanding and review of literature". Current Opinion in Hematology. 25 (1): 3–6. doi:10.1097/MOH.0000000000000392. PMID 29211696. S2CID 37034947.
- ↑ Gorup, T; Cohen, A. T.; Sybenga, A. B.; Rappaport, E.S. (2018). "Significance of green granules in neutrophils and monocytes". Proceedings (Baylor University Medical Center). 31 (1): 94–96. doi:10.1080/08998280.2017.1391045. PMC 5903543. PMID 29686568.
- ↑ Harris, V.; Malysz, J.; Smith, M. (2009). "Green neutrophilic inclusions in liver disease". Journal of Clinical Pathology. 62 (9): 853–854. doi:10.1136/jcp.2009.064766. PMID 19734487. S2CID 7388473.
- 1 2 Hodgson, T; Roskova, A.; Shugg, C.; McCallum, V.; Morison, I. (2015). "Green neutorphil and monocyte inclusion - time to acknowledge and report". British Journal of Haematology. 170 (2): 229–235. doi:10.1111/bjh.13434. PMID 25892703. S2CID 23809865.
- ↑ Courville, E. L.; Crisman, S.; Linden, M. A.; Yohe, S. (2017). "Green Neutrophilic Inclusions are Frequently Associated With Liver Injury and May Portend Short-Term Mortality in Critically Ill Patients". Laboratory Medicine. 48 (1): 18–23. doi:10.1093/labmed/lmw064. PMID 28039379.